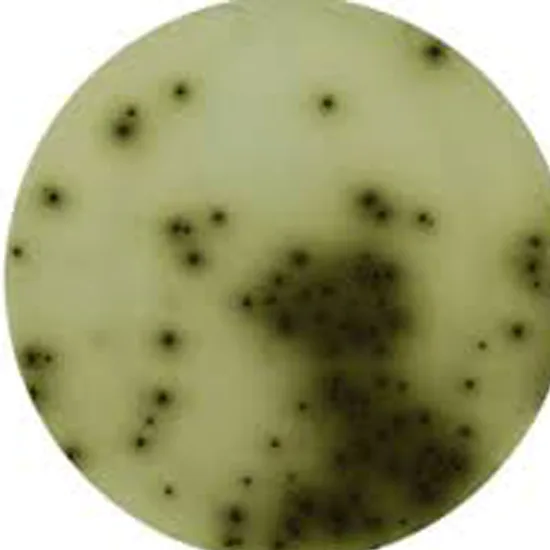

Book Bismuth, 24 Hour Urine Appointment Online Near me at the best price in Delhi/NCR from Ganesh Diagnostic. NABL & NABH Accredited Diagnostic centre and Pathology lab in Delhi offering a wide range of Radiology & Pathology tests. Get Free Ambulance & Free Home Sample collection. 24X7 Hour Open. Call Now at 011-47-444-444 to Book your Bismuth, 24 Hour Urine at 50% Discount.
Book Bismuth, 24 Hour Urine Test at the best price in Delhi NCR, India from GDIC (Ganesh Diagnostic & Imaging Centre). GDIC is a NABL Accredited Pathology lab in Delhi offering a wide range of lab tests.
Bismuth, 24 Hr urine Test is a blood sample test. It is used in two very different applications. The majority is consumed in bismuth alloys, pharmaceuticals, and chemicals. The remainder is used in paints, ceramics, catalysts, and a variety of minor applications. In pharmaceuticals, Bismuth is most commonly used in the eradication of Helicobacter pylori, the causative agent for diseases like gastritis, peptic ulcer, and even gastric cancer.
This diagnostic test is conducted to identify Renal Disorder in a human body and also during and after treatment of Gout in a human body.
You need to provide your whole blood.
No preparation is needed.
No care is required.
The Bismuth, 24-hour Urine Test costs vary from INR 3000 to INR 15000 by region and facility. So, get tested at trustworthy diagnostic centers like Ganesh Diagnostic. Training and experienced professionals are staffed to assure patient and visitor safety.
| Test Type | Bismuth, 24 Hour Urine |
| Includes | Bismuth 24 Hour Urine Test (Hematology) |
| Preparation | |
| Reporting | Within 24 hours* |
| Test Price |
₹ 3500
|

Early check ups are always better than delayed ones. Safety, precaution & care is depicted from the several health checkups. Here, we present simple & comprehensive health packages for any kind of testing to ensure the early prescribed treatment to safeguard your health.